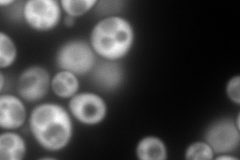
YPR080W
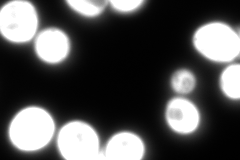
YPR080W
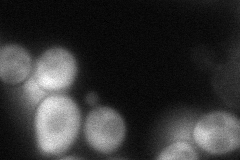
YPR080W

View description
Translational elongation factor EF-1 alpha; also encoded by TEF2; functions in the binding reaction of aminoacyl-tRNA (AA-tRNA) to ribosomes; may also have a role in tRNA re-export from the nucleus
Localization:
Intensity:
Fold change:
Significance:
-
C’ GFP library in SD

cytosol3135.68 -
N' NOP1pr-GFP in SD
cytosol561.143 -
N' TEF2pr-mCherry in SD

cytosol420.804 -
N' NATIVEpr-GFP in SD
cytosol3530.97 -
N' TEF2pr-VC and Cyto-VN in SD
cytosol83.0529 -
C’ GFP library in SD+DTT

cytosol2806.680.89No -
C’ GFP library in SD+H2O2

cytosol3261.821.04No -
C’ GFP library in Starvation Media

cytosol1937.760.61Yes -
C’ GFP library on the background of Pup2-DaMP

cytosol -
C’ GFP library on the background of CCT mutant

cytosol3261.821.04023No
